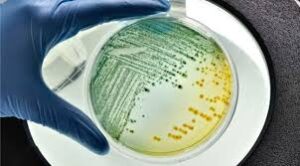

Stricter official regulations will soon come into force to ensure that in the future, healthier – or at least less harmful – drinking water comes out of the tap or is bottled and placed on our tables.
About drinking water regulations
Drinking water is classified as a foodstuff, which is subject to strict legal regulations in the EU and separate national drinking water safety regulations in each member state.
- Directive (EU) 2020/2184: This directive sets out the quality requirements for drinking water in the European Union.
- WHO Guidelines for Drinking Water Quality: These internationally recognized guidelines form the basis for EU directives and also include the water safety plan approach.
- EN 15975-2 standard: A standard for the safety of drinking water supply that implements safety requirements in practice.
Drinking water quality requirements and control
Tap water is one of the most frequently and strictly controlled products. The problem is that water quality is usually checked by water suppliers, not consumers. The problem with this is that, after traveling through miles of outdated water pipes, it is no longer certain that the water reaching the consumer is of adequate quality! Another concern is that the parameters currently being tested are incomplete and the permissible limits are too lenient.
Important change in European regulations from the beginning of next year
European water utility providers, which often struggle with a lack of resources, are already facing challenges in complying with the current legal limits. This will become even more difficult from January 12, 2026, when the European Union introduces new, stricter drinking water quality rules.
The goal is to filter out pollutants that pose a long-term health risk and have rarely or never been monitored before.
New drinking water parameters coming into force
Below, we list the eight new mandatory parameters and the two substances on the watch list, showing why and how these substances can end up in tap water.
 PFAS – “forever chemicals”
PFAS – “forever chemicals”
- Limit value: total PFAS ≤ 0.50 µg/L (or sum of 20 designated compounds ≤ 0.10 µg/L)
- What are they? Fluorinated surfactants, extremely stable, can take centuries to degrade
- Source: firefighting foam, textile/leather and paper coatings, microchip manufacturing, household contaminants
- Risk: hormonal, liver, and immune system disorders
- Haloacetic acids (HAA, total)
- Limit value: ≤ 60 µg/L
- Formation: reaction of chlorination with natural organic substances
- Where does it appear? Surface water disinfected with chlorine, long pipe networks, warm summer water
- Risk: potential carcinogenic and kidney damage effects
- Chlorate
- Limit value: ≤ 0.25 mg/L
- Origin: decomposition of hypochlorite solution
- Why is it harmful? It can inhibit thyroid hormone production in children
- Chlorite
- Limit value: ≤ 0.25 mg/L
- Origin: chlorine dioxide disinfection
- Why is it harmful? It can inhibit thyroid hormone production in children
- Microcystin LR
- Limit value: ≤ 1 µg/L (measurement only mandatory in case of algal bloom risk)
- Source: toxin produced by blue/green algae in eutrophic lakes and slow-flowing rivers
- Risk: strong liver toxin, suspected carcinogen in WHO Group IV
- Bisphenol A (BPA)
- Limit value: ≤ 2.5 µg/L
- Source: polycarbonate bottles, epoxy resin lining in drinking water pipes and tanks
- Risk: endocrine disruptor, developmental disorders
- Uranium
- Limit value: ≤ 30 µg/L (for chemical toxicity; radioactivity is regulated separately)
- Source: natural rock dissolution (granite, volcanic rock), less commonly mining
- Risk: kidney damage, bone metabolism disorders
- Legionella spp.
- Limit value: ≤ 1,000 CFU/L (mainly in hot water systems)
- Where does it multiply? Stagnant water at 25–45 °C, boilers, cooling towers, shower head biofilm
- Risk: Legionnaires’ disease, severe pneumonia
Watch list – alert thresholds
| Substance | Value | Main source |
| β estradiol | 1 ng/L | wastewater, animal husbandry |
| Nonylphenol | 0,30 µg/L | detergents, textile industry |
| These are not “limit values,” but if they rise above the threshold, increased sampling and risk management are mandatory! | ||
Will stricter regulations be compatible with reality?
I fear that legislation will not solve quality concerns at a stroke. The problem cannot be solved by imposing fines or closing down a waterworks, and the available industrial water treatment technology is not capable of economically purifying large quantities of water entering from potentially contaminated drinking water sources.
People must be supplied with water one way or another, because without it there is no life! I could mention the UN Charter or the Mexican Constitution, which recently added that every person has the fundamental right to access healthy drinking water. Despite this, people around the world are thirsty, and Mexico is facing a complete disaster due to water shortages…
In Europe, too, the reality is likely to be that the new bureaucratic measure will be difficult or impossible to enforce or sanction, and will probably not solve the water quality problems that arise in a given location. In our case, too, the aphorism that a rule is only as good as its enforcement is likely to be true. I’m afraid that after January 12th, the same quality of water will flow from our taps as it does now.
Find out what kind of water you are drinking!
I don’t want to scare anyone with terms such as “forever chemicals” PFAS and microplastics and their effects on the human body. A study published two weeks ago in the American Journal of Pathology discusses in detail the links between micro- and nanoplastics and vascular mortality. The latest research shows that PFAS substances can cause serious nervous system problems when incorporated into human DNA, as I wrote about in a blog post last year. If you are interested in this horror story, read up on it at your own risk! But I would also give you another useful piece of advice: take a sample of tap water to an accredited drinking water testing laboratory to find out if you have cause for concern!
Healthy drinking water from the atmosphere
WizzWell atmospheric water generators (AWG) extract water from the purest source, the air. This is purified by a state-of-the-art filtration system and, after mineralization and UV sterilization, the machine’s water dispenser always provides fresh, healthy, and tasty drinking water for households, small or even large communities.



For the reason that the admin of this site is working, no uncertainty very quickly it will be renowned, due to its quality contents.
There is definately a lot to find out about this subject. I like all the points you made
naturally like your web site however you need to take a look at the spelling on several of your posts. come again again. lüleburgaz şehir içi nakliyat
Dear Lüleburgaz! Thank you for your feedback! It is an achievement of the 21st century that news and information can reach Turkish, Chinese, French, German, Spanish, etc. readers, and they can read it in their own language. This is provided by a paid translation engine. I apologize if the language of the translations is not perfect. Thank you for your understanding!
Hi there to all, for the reason that I am genuinely keen of reading this website’s post to be updated on a regular basis. It carries pleasant stuff.
Great article highlighting the growing concerns about drinking water safety and the upcoming stricter EU regulations. It’s a timely reminder to be proactive about what we consume. This makes me wonder about the broader health implications, especially for travelers who might be exposed to different water sources and subsequently face health issues like acute diarrhea. I came across a detailed guide on managing this exact problem while traveling, which seems relevant to the discussion about water quality and health. Sorry for dropping a link here, but it helps clarify what I’m referring to: https://pillintrip.com/article/acute-diarrhea-a-travelers-guide-to-staying-healthy-on-the-move. Given the potential contaminants listed in the article (like bacteria and parasites), what practical advice would you offer to travelers who are concerned about water safety and its direct impact on digestive health, especially in regions where the new EU standards might not yet be enforceable?
Nice article! I especially liked the actionable checklist.